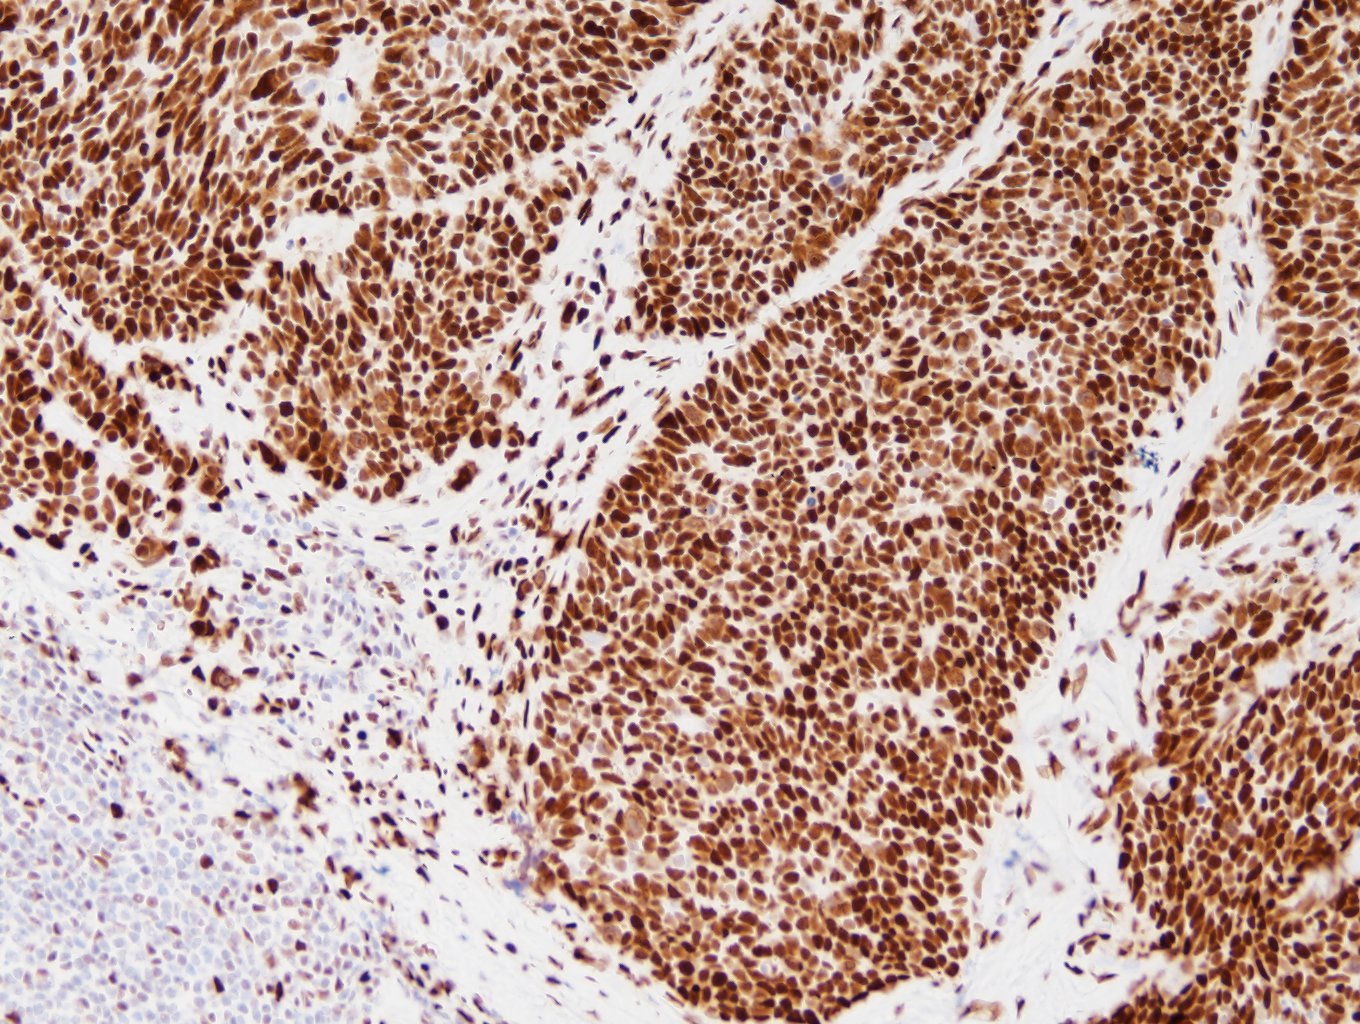
小細胞肺癌（SLFN11陽性例）

IHC・ISH試薬 Molecular Diagnostics Division
保管温度2~8℃
用手法用 ヒストステイナー用 ヒストステイナーAT用
SLFN11Schlafen 11
■動物種:ウサギ
■クローン名:EPR24414-87
■使用目的:組織・細胞中のヒトSLFN11タンパク質の染色
ホルマリン固定パラフィン包埋切片の免疫染色に使用できる。
研究用としてのみ使用すること。
■資料
リーフレット
スクロールで確認できます→
用手法用
ヒストステイナー用
ヒストステイナーAT用
※弊社へお問い合わせください
特異性および抗原分布
ヒトSLFN11(Schlafen 11)タンパク質と特異的に反応する。SLFN11は、ヒト17番染色体(17q12)に位置するSLFN11遺伝子にコードされる核内タンパク質であり、DNA複製ストレスに応答して細胞死を誘導する(1)~(3)。DNA障害型抗がん剤(白金製剤、トポイソメラーゼ阻害剤など)は、複製フォークの進行を妨げるなどのDNA複製ストレスを引き起こすことが知られており、SLFN11はこれらの薬剤に対する感受性を高める因子として報告されている(2)~(4)。正常では、肺胞上皮細胞や気管支上皮細胞で発現がみられることがあるが、大腸、前立腺の上皮細胞ではほとんど発現がみられない(4)(5)。腫瘍では、胃がん、卵巣がん、肺がんなどで発現がみられることがある一方、大腸がん、前立腺がんなどではSLFN11を発現する症例の割合は限られることが報告されている(4)(5)。また、SLFN11は炎症性細胞や腫瘍間質細胞にも発現がみられることがあることから、腫瘍組織を用いたRNA解析では腫瘍細胞以外の細胞成分の影響によりSLFN11発現が過大評価される可能性があり、正確な評価には免疫組織化学染色が有用であると報告されている(4)(5)。SLFN11はDNA障害型抗がん剤に対する効果予測のバイオマーカーとなる可能性が示唆されており、特に胃がん、卵巣がん、小細胞肺癌、頭頸部扁平上皮癌においては、SLFN11の高発現とDNA障害型抗がん剤の薬剤感受性との高い相関が示されている(6)~(10)。
文献
(1) Jo U, et al. Structural, molecular, and functional insights into Schlafen proteins. Exp Mol Med. 2022 Jun;54(6):730-738.
(2) Murai J, et al. Schlafen 11 (SLFN11), a restriction factor for replicative stress induced by DNA-targeting anti-cancer therapies. Pharmacol Ther. 2019 Sep;201:94-102.
(3) Zoppoli G, et al. Putative DNA/RNAhelicase Schlafen-11 (SLFN11) sensitizes cancer cells to DNA-damaging agents. Proc NatlAcad Sci U S A. 2012 Sep 11;109(37):15030-5.
(4) Takashima T, et al. Immunohistochemical analysis of SLFN11 expression uncovers potential non-responders to DNA-damaging agents overlooked by tissue RNA-seq. VirchowsArch. 2021 Mar;478(3):569-579.
(5) Kaczorowski M, Ylaya K, Chłopek M, Taniyama D, Pommier Y, Lasota J, Miettinen M. Immunohistochemical Evaluation of Schlafen 11 (SLFN11) Expression in Cancer in the Search of Biomarker-Informed Treatment Targets:AStudy of 127 Entities Represented by 6658 Tumors.Am J Surg Pathol. 2024 Dec 1;48(12):1512-1521.
(6) Zhou K, et al. SLFN11: a pan-cancer biomarker for DNA-targeted drugs sensitivity and therapeutic strategy guidance. Front Oncol. 2025 Jul 22;15:1582738.
(7)Takashima T, et al. Schlafen 11 predicts response to platinum-based chemotherapy in gastric cancers. Br J Cancer. 2021 Jul;125(1):65-77.
(8)Onji H, et al. Schlafen 11 further sensitizes BRCA-deficient cells to PARP inhibitors through single-strand DNAgap accumulation behind replication forks. Oncogene. 2024 Aug;43(32):2475-2489.
(9)Willis SE, et al. Retrospective analysis of Schlafen11 (SLFN11) to predict the outcomes to therapies affecting the DNA damage response. Br J Cancer. 2021 Dec;125(12):1666-1676.
(10)HamadaS, et al.Schlafenfamilymember 11 indicates favorable prognosis of patients withhead andneckcancer following platinum-basedchemoradiotherapy. FrontOncol. 2023 Jan 19;12:978875.

食道



